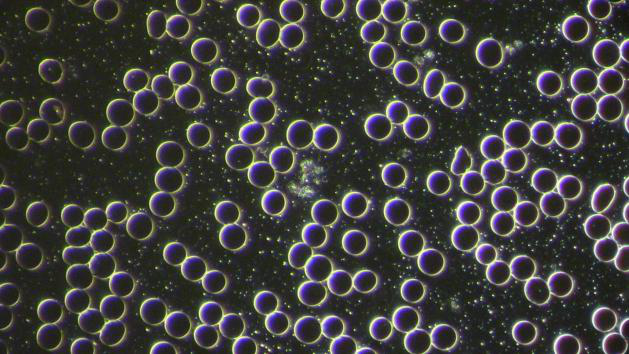
cold laser2

Cold Laser
Le laser à froid, également appelé la thérapie laser de bas niveau (LLLT, Low Level Laser Therapy), utilise des photons inoffensifs non thermiques pour accélérer les processus de guérison naturelle du corps. Cette énergie lumineuse peut pénétrer à travers toutes les couches de notre peau avec facilité. C’est particulièrement utile contre les douleurs, les problèmes articulaires et neurologiques, les blessures et les brûlures, les problèmes dentaires, le gonflement des ganglions lymphatiques, les acouphènes et la régénération des os / tissus, ainsi que de nombreuses autres applications.
Alors qu’il recherchait sur les cellules cancéreuses en 1974, le professeur Fritz-Albert Popp a fait la découverte étonnante que toutes les cellules stockent des photons de lumière, en particulier autour de l’ADN. Il a montré que le cancer et d’autres cellules malades ont un niveau significativement différent d’émission de photons par rapport aux cellules normales, et a théorisé que cette lumière interne stockée prend peut-être une part importante dans la façon dont les cellules communiquent entre elles dans le corps, afin de maintenir une bonne santé générale. Des recherches russes faites ultérieurement sur l’ADN ont validé ses conclusions. Les utilisations thérapeutiques du laser froid sont soutenues par de nombreuses études médicales.
Observons l’action d’une exposition de 45 minutes par Laser Froid sur des cellules sanguines.
La thérapie au laser à froid est normalement appliquée pendant 30 minutes, mais les temps plus longs peuvent être envisagés. Spooky Cold Laser Wrist est conçu pour être porté autour du poignet, où il peut facilement traiter la circulation sanguine, le canal carpien, et le complexe méridien, mais il peut également être utilisé pour d’autres domaines. Spooky Cold Laser Twin est utilisé pour une application précise dans n’importe quelle zone du corps, et peut être utilisé dans la bouche, ou inséré dans les canaux de l’oreille et les narines.
L’une ou l’autre unité se connecte directement à Out 1 d’un générateur Spooky2-5M, ou à Out 1 d’un Spooky Boost 3.0, et peut être pulsée par des fréquences.

